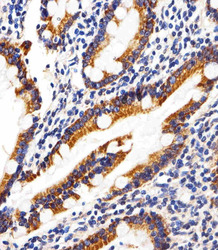

Antibody data
- Antibody Data
- Antigen structure
- References [0]
- Comments [0]
- Validations
- Western blot [1]
- Immunohistochemistry [1]
Submit
Validation data
Reference
Comment
Report error
- Product number
- LS-C344253 - Provider product page

- Provider
- LSBio
- Product name
- SHB Antibody (Tyr268) LS-C344253
- Antibody type
- Polyclonal
- Description
- Protein A purified
- Reactivity
- Human
- Host
- Rabbit
- Storage
- Maintain refrigerated at 2°C to 8°C for up to 6 months. For long term storage store at -20°C.
No comments: Submit comment
Enhanced validation
- Submitted by
- LSBio (provider)
- Enhanced method
- Genetic validation
- Main image

- Experimental details
- Western blot of lysates from HepG2, Jurkat, K562, HUVEC cell line (from left to right) with SHB-Y268 Antibody. Antibody was diluted at 1:1000 at each lane. A goat anti-rabbit IgG H&L (HRP) at 1:5000 dilution was used as the secondary antibody. Lysates at 35 ug per lane.
Supportive validation
- Submitted by
- LSBio (provider)
- Enhanced method
- Genetic validation
- Main image
- Experimental details
- Immunohistochemical of paraffin-embedded H. small intestine section using Phospho-HUMAN-SHB (Y268). control. Antibody was diluted at 1:25 dilution. A peroxidase-conjugated goat anti-rabbit IgG at 1:400 dilution was used as the secondary antibody, followed by DAB staining.